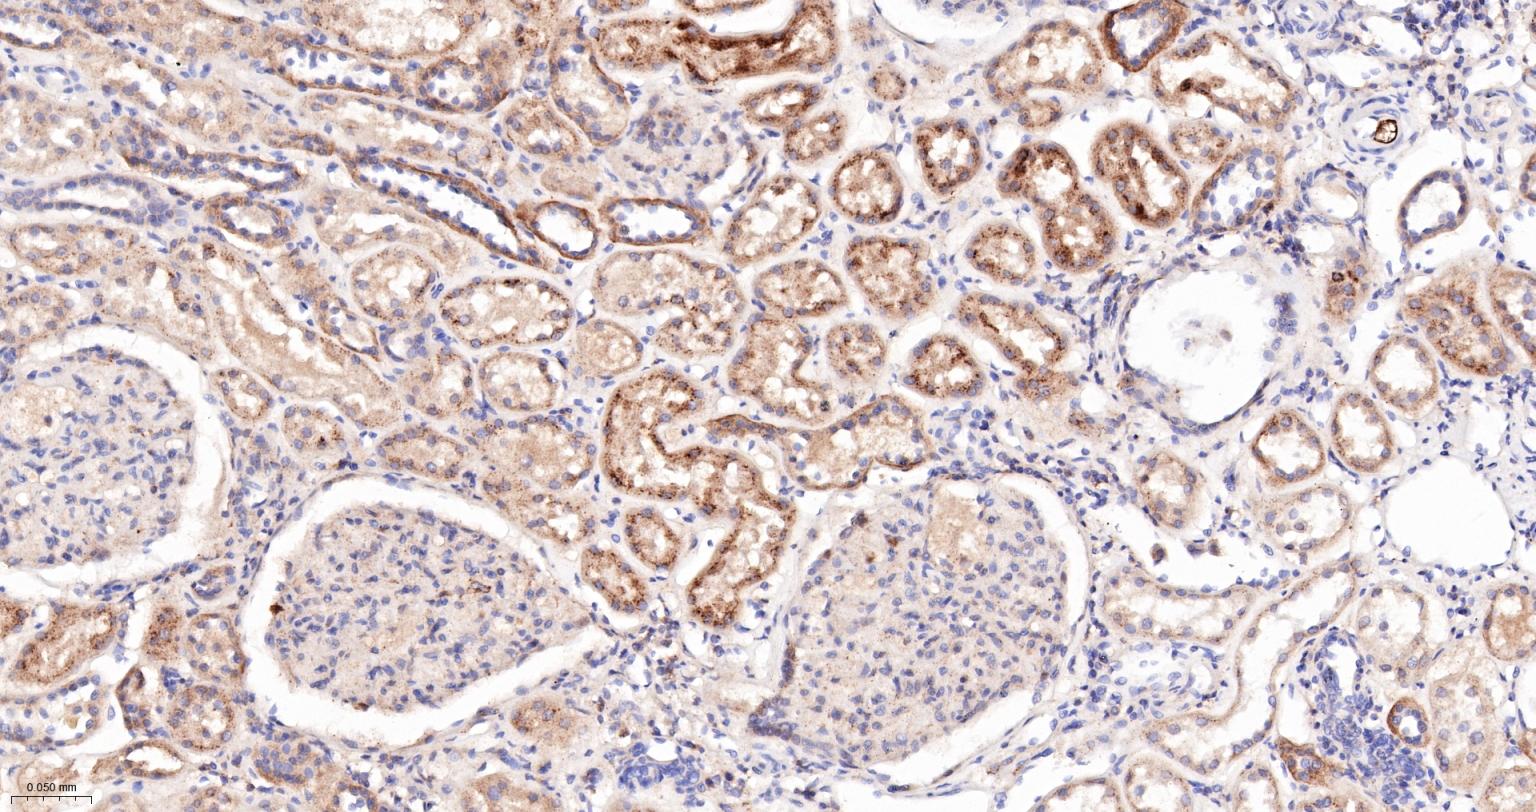
组织蛋白酶B重组兔单抗
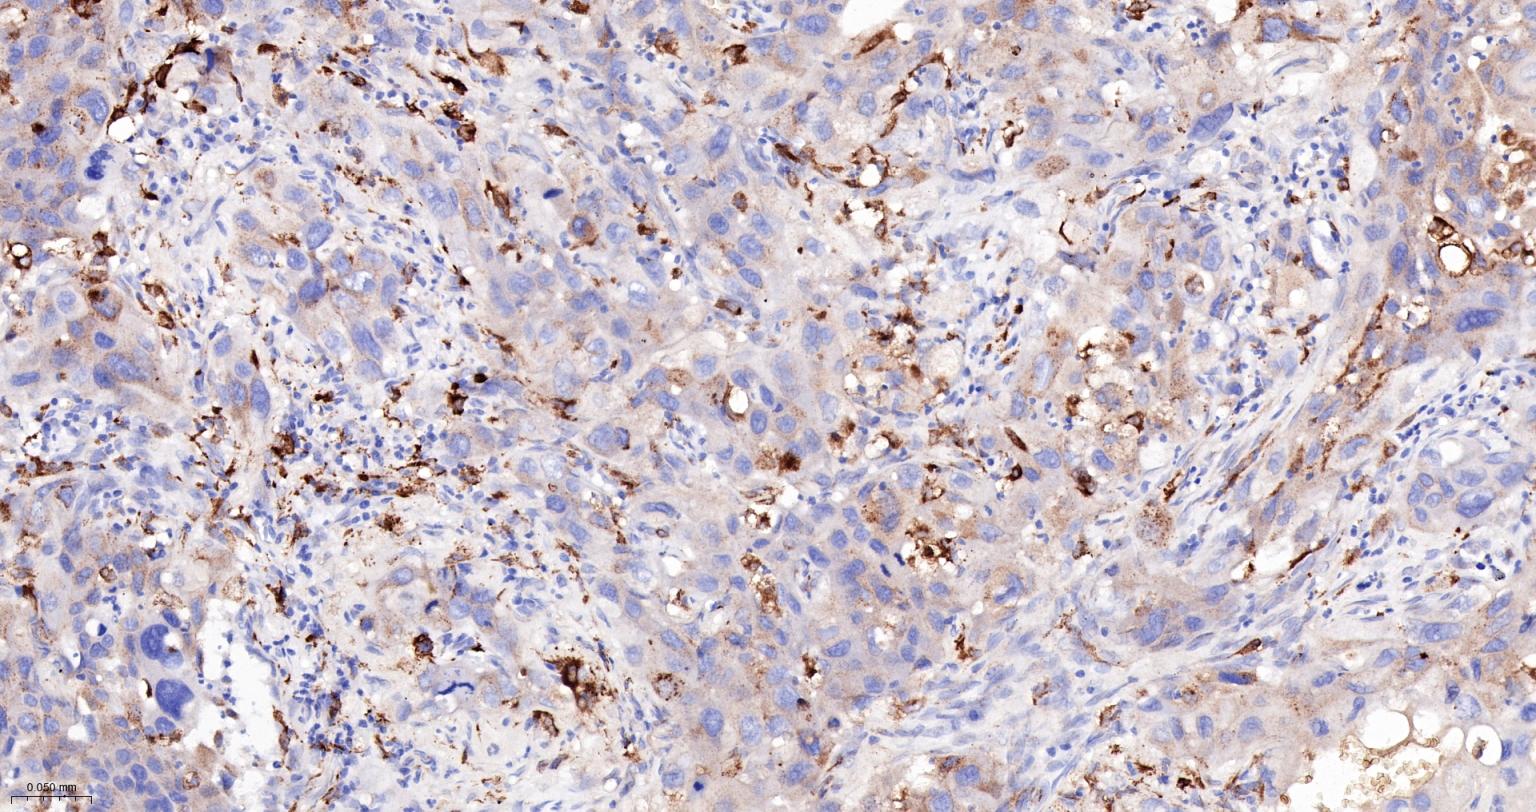
组织蛋白酶B重组兔单抗

组织蛋白酶B重组兔单抗
Rrmab?兔单抗

货号:bsm-61441R
产品详情
相关标记
相关产品
相关文献
常见问题
概述
产品编号
bsm-61441R
产品类型
重组兔单抗
英文名称
Cathepsin B Recombinant Rabbit mAb
中文名称
组织蛋白酶B重组兔单抗
英文别名
APPS; CPSB; KWE; RECEUP; CB; CATB_HUMAN; CTSB; APP secretase (APPS); Cathepsin B1; 3.4.22.1; CATB_MOUSE; CATB_RAT; RSG-2;
抗体来源
Rabbit
免疫原
A synthesized peptide derived from human Cathepsin B: 2-180
亚型
IgG
性状
Liquid
纯化方法
affinity purified by Protein A
克隆类型
Recombinant
克隆号
14C12
理论分子量
38 kDa
检测分子量
38 kDa
储存液
10mM phosphate buffered saline(pH 7.4) with 150mM sodium chloride, 0.05% BSA, 0.02% Proclin300 and 50% glycerol.
研究领域
Cancer > Invasion/microenvironment > Angiogenesis > ECM enzymes > Cathespins
Cancer > Invasion/microenvironment > ECM > Cell adhesion
Cancer > Invasion/microenvironment > ECM > Extracellular matrix
Kits/ Lysates/ Other > Kits > ELISA Kits > ELISA Kits > Adhesion molecules ELISA kits
Neuroscience > Cell Adhesion Proteins > Membrane Proteins
Signal Transduction > Cytoskeleton / ECM > Extracellular Matrix > ECM Enzymes > Other Enzymes
SWISS
Gene ID
保存条件
Store at 4℃ for short term. Store at -20℃ for long term. Avoid repeated freeze/thaw cycles.
注意事项
This product as supplied is intended for research use only, not for use in human, therapeutic or diagnostic applications.
数据库链接
产品介绍
合成与降解(Synthesis and Degradation)
组织蛋白酶B(CB) 参与肿瘤的侵袭转移过程。可促进肿瘤血管的增生,增强肿瘤细胞的运动能力.组织蛋白酶B转录以及表达水平的高低与肿瘤预后呈正相关。
cathepsin B属于半胱氨酸蛋白酶,与人体的多种生理、病理过程密切相关.组织蛋白酶B (cathepsin B,CB)主要存在于溶酶体中, 发挥其生理状态下的蛋白水解作用.但在某些特定条件下, CB在胞外间质中有时也可以检测到.
目前,有学者将CB用于阿尔茨海默病(AD)方面的研究。
组织蛋白酶B(CB) 参与肿瘤的侵袭转移过程。可促进肿瘤血管的增生,增强肿瘤细胞的运动能力.组织蛋白酶B转录以及表达水平的高低与肿瘤预后呈正相关。
cathepsin B属于半胱氨酸蛋白酶,与人体的多种生理、病理过程密切相关.组织蛋白酶B (cathepsin B,CB)主要存在于溶酶体中, 发挥其生理状态下的蛋白水解作用.但在某些特定条件下, CB在胞外间质中有时也可以检测到.
目前,有学者将CB用于阿尔茨海默病(AD)方面的研究。
背景资料
Thiol protease which is believed to participate in intracellular degradation and turnover of proteins. Cleaves matrix extracellular phosphoglycoprotein MEPE. Involved in the solubilization of cross-linked TG/thyroglobulin in the thyroid follicle lumen.

产品应用
| 应用 | 已检合格种属 | 预测种属 | 推荐稀释比例 |
|---|---|---|---|
| WB | Human | 1:1000-2000 | |
| IHC-P | Human | 1:100-500 | |
| IHC-F | Human | 1:100-500 | |
| IF | Human | 1:100-500 | |
| ICC/IF | Human | 1:50-200 | |
| IP | Human | 1:20-50 |
交叉反应
交叉反应: Human
相关产品
暂无相关产品
靶标
基因名
CTSB
蛋白名
Cathepsin B
亚基
Dimer of a heavy chain and a light chain cross-linked by a disulfide bond. Interacts with SRPX2.
亚细胞定位
Lysosome. Melanosome. Note=Identified by mass spectrometry in melanosome fractions from stage I to stage IV.
相似性
Belongs to the peptidase C1 family.
功能
Thiol protease which is believed to participate in intracellular degradation and turnover of proteins. Has also been implicated in tumor invasion and metastasis.
标记抗体
暂无标记数据
同靶标产品
暂无同靶标产品
相关文献
提示: 发表研究结果有使用 bsm-61441R 时请让我们知道,以便我们可以引用参考文章。作为回馈,资料提供者将获得我们送上的小礼品。
暂无相关文献
常见问题
暂无常见问题